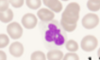
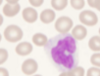
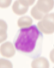
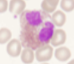
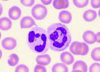
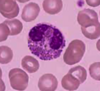
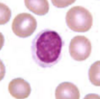

What is blood?
A specialised fluid (Tissue) composed of a variety of cellular components suspended in a liquid known as plasma
How are blood components separated?
Centrifugation
What are the 3 layers of centrifuged blood?
Plasma - Top
Buffy coat
Erythrocyte layer - Bottom
What is contained in the buffy coat layer of centrifuged blood?
Platelets and leukocytes
What is the haematocrit?
The percentage of blood that is formed of erythrocytes
What is the average male haematocrit?
42
What is the average female haematocrit?
38
What is the lifespan of a red blood cell?
120 days
What is the lifespan of a neutrophil?
7-8 hours
What is the lifespan of a platelet?
7-10 days
What is haemopoiesis?
The formation of blood cells
What is the process of forming erythrocytes called?
Erythropoiesis
What is the process of forming platelets called?
Thrombopoiesis
What is the process of forming granulocytes called?
Myelopoiesis or granulopoiesis
What is the process of forming lymphocytes called?
Lymphopoiesis
What are blasts?
Nucleated blood cell precursor cells
What are megakaryocytes?
Multi-nucleated platelet precursor cells
What are reticulocytes?
Immediate red cell precursor cells
What are myelocytes?
Nucleated precursor cells between neutrophils and myeloblasts
What are some definitions of “myeloid”?
Bone marrow
Non-lymphoid lineage
Granulocytes and precursor pathways
What is meant by red marrow?
Haemopoietically active bone marrow
What is meant by yellow marrow?
Fatty, inactive bone marrow
How is yellow marrow effected by age?
Percentage of yellow marrow increases with age
What is the myeloid:erythroid ratio?
Relationship of neutrophils and precurosrs to proportion of nucleated red cell precursors (Range from 1.5:1 - 3.3:1) - This can change such as in reversal in haemolysis as a compensatory response